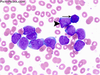
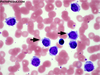
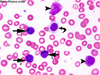
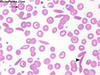
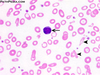

Blood Flashcards
(41 cards)
What is the lifespan of erythrocytes?
120 days
What is the lifespan of leukocytes?
From 12 hours to years
What is the liefespan of platelets?
8-10 Days
What is the leukocyte labeled A?

Band Neutrophil
What is the leukocyte labeled B?

Lymphocyte
What is the leukocyte labeled C?

Monocyte
What is the leukocyte labeled D?

Eosinophil
What is the leukocyte labeled E?

Segmented Neutrophil
What is the leukocyte labeled F?

Basophil
Where are blood type antibodies located?
Plasma
What type of homeostatic imbalance is pictured?
Acute Myelogenous Leukemia
What type of homeostatic imbalance is pictured?

Chronic Myelogenous Leukemia (from a bone marrow aspirate)
What type of homeostatic imbalance is this?

Plasma Cell Leukemia
What type of homeostatic imbalance is this?
Hairy cell leukemia
What type of homeostatic imbalance is this?

Acute lymphoblastic Leukemia
What type of homeostatic imbalance is this?
Chronic Lymphocytic Leukemia
What type of homeostatic imbalance is this?
Sickle cell Disease
What type of homeostatic imbalance is this?
Iron Deficiency Anemia
What type of homeostatic imbalance is this?

Megaloblastic Anemia
What type of homeostatic imbalance is this?

Thalassemia
What is the function of Neutrophils?
Most common in the blood, phagocyte
What is the function of Eocinophils?
Fight off paracitic worms, show up after allergic reaction
What is the function of Basophils?
Fights allergens
What is the function of Lymphocytes?
B cells and T cells, remember past pathogen exposure


